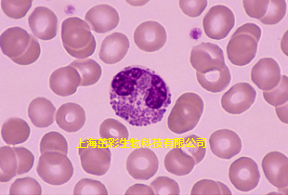
间苯二酚碱性品红染色.png

ZC1047 间苯二酚碱性品红染色
2022-02-23
实验收费标准:
| 项目编号 | 项目名称 | 计价单位 | 单价 |
ZC1047 | 间苯二酚碱性品红染色 | 张 | 30元 |
实验结果展示:
实验流程:
1、石蜡切片脱蜡至水:依次将切片放入二甲苯Ⅰ20min-二甲苯Ⅱ20min-无水乙醇Ⅰ5min-无水乙醇Ⅱ5min-75%酒精5min,自来水洗。
2、氧化:酸化高锰酸钾(高锰酸钾:硫酸=1:1混合)氧化5min,自来水洗。
3、漂白:草酸溶液漂白1-2min,至无色,流水冲洗2min,95%的乙醇稍浸洗。
4、间苯二酚碱性品红染色:切片入间苯二酚品红染液中浸染并加盖,室温下3~4h,流水冲洗。
5、背景分化:盐酸酒精分化至无染液脱下,弹力纤维清晰的紫红色,背景淡紫或近乎无色。
6、复染VG:将饱和苦味酸与酸性品红9:1混合成VG染液,染1-3min,快速水洗,无水乙醇三缸快速脱水。
7、透明封片:干净的二甲苯透明1-5min,中性树胶封片。
8、显微镜镜检,图像采集分析。
结果判读:
弹力纤维紫红色,胶原纤维红色,背景其他成分黄色
注意事项:
1、VG复染过程中水洗要快,防止红色褪掉,无水乙醇也要快洗,防止黄色变暗。